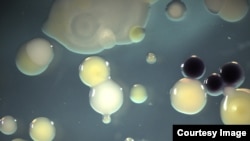
Microbes can help fight pollution.

Hello, my friends, and welcome back as we work together to improve your American English.
I’m Jim Tedder in Washington.
Today we will learn more about our changing climate. In two important stories, we will examine how the oceans are helping in unusual ways to solve difficult problems.
As It Is …is coming to you from VOA in Washington.
Coral Reefs Are Dying
Coral reefs are home to about one-third of everything that lives in the ocean. Reefs help protect coastal areas from storm damage. They also provide food and jobs for about 1 billion people worldwide. But rising ocean temperatures and increasing levels of acidity are killing many coral reefs.
As much as 80 percent of the corals in the Caribbean Sea are dead.
Mario Ritter tells about a new study of heat-resistant corals, and how they may be able to help protect reefs in a warmer world.
Researchers have been studying a single coral species from the Pacific Ocean. The corals live in two different, but neighboring ponds on the same reef in American Samoa. The only difference is that water in one area is warmer than the other. Researchers want to know how increasing temperatures affect the corals.
Corals from the cooler pond were put into the warmer water. After about a year, those transplanted corals were tested in devices called laboratory heat stress tanks. The transplants were about half as heat-tolerant, or resistant, as corals that had been living in the warmer water.
Stephen Palumbi is a marine biologist with Stanford University in California. He says the newcomers reacted quickly to their new surroundings, compared to how the creatures would naturally evolve over time. He spoke to VOA on Skype.
“We estimate that it would take about 50 to 100 years for evolution to generate this kind of change, mostly because corals are very long-lived animals and the generation time is quite long. So evolution works fairly slowly in those cases, whereas the physiology seems to react very quickly to changes in the local environment and then buffer these individual corals against heat stress.”
But he says the coral species living in the warmer ocean water were more resistant to heat.
“They had the genes to be able to live there. And they also had the physiology to be able to adjust to it. The corals from the cool pool had the physiology, too. But they didn’t have the warm water genes.”
Stephen Palumbi says the study suggests that as the ocean warms, some corals can react in time, but not, he fears, as quickly as the planet heats up.
“But this ability to respond physiologically and evolutionarily might give them a few extra decades, might give them a little extra time to adjust to climate change. It gives us a little extra time to fix the problem.”
The American researcher says the study results could persuade decision makers to set goals to protect coral reefs with heat-resistant corals. He adds that as ocean temperatures rise, these organisms could help damaged reefs re-build.
I’m Mario Ritter.
Little Bugs Can Help Us
Four years ago, 11 people were killed in an explosion on an oil rig called the Deepwater Horizon. The large drilling platform leaked an estimated five million barrels of oil into the Gulf of Mexico. It was the largest environmental disaster at sea in American history, but it is not the only one. About 14,000 oil spills are reported in the United States each year, says the Environmental Protection Agency.
Cleaning up the mess from these spills is usually a long and expensive process. But scientists now say an extremely small organism can help clean up naturally occurring, or man-made leaks of natural gases.
They have identified some 100 microbes that feed on methane, a byproduct of natural gas. Methane has also been linked to rising temperatures on Earth’s surface. It is a climate-changing gas that warms the atmosphere.
A report in the journal Nature examines the genetic structure of a single strain, or form, of bacteria. It is called Methylocella Silvestris. This microbe is found in forests and soils in northern Europe. It was also found in the Gulf of Mexico after the Deepwater Horizon spill.
Colin Murrell is an environmental microbiologist with the University of East Anglia in England.
“We tested for growth on propane and sure enough it grows very happily on propane as well as methane. This is the uniqueness of the work that we’ve got one organism that seems to be able to acquire the ability to grow on these different gases together.”
But growth in a controlled laboratory experiment is from different from what happens in a natural environment. That is why researchers want to understand how the microbes work, and what influences their behavior.
“…what enzymes and what genes are being used by that bacterium to grow on either methane or propane. And then we can start to build up a picture of whether they are going to be useful in a sort of commercial context in terms of cleanup of oil spills or cleanup of a whole variety of different compounds.”
Colin Murrell says he is sure that other microbes in the environment work in similar ways. He believes that he has the tools to find them.
“We have specific gene and molecular probes that we can use to go back and interrogate environmental samples to see if these organisms are present there in the first place.”
He says the findings can help explain the possible use of microbes to decision-makers.
“In terms of cleanup of the environment or in context of different organisms, making useful chemicals in a biologically clean way rather than using a lot of hazardous chemicals. So green chemistry, if you like.”
Colin Murrell says the effect of methane on climate change is more than 20 times greater than that of carbon dioxide. He says, ‘It is important to understand how it can be removed naturally in the environment before it is released into the atmosphere.’
An American History Lesson
We have just enough time to throw in a small American history lesson …for free! On this date in 1942, the Battle of the Coral Sea took place. The United States was fighting Japan during World War II. It happens that all the fighting was done in this battle with airplanes. That was a first in military history. The U.S. won the battle, and it helped stop Japan from expanding that part of their war effort.
Today is also V-E Day, Victory in Europe day. It was on this date in 1945 that Germany surrendered to Allied forces. At the time, the President of the United States was Harry S. Truman. And oddly enough, May 8th was his birthday. Mr. Truman was known for his plain speaking, and was often called “Give ‘em hell Harry” by the people who liked his style.
Well, that is all the time we have for today.
More Learning English programs will soon be here, and we will have world news at the beginning of the hour.
I’m Jim Tedder in Washington …and this is VOA!